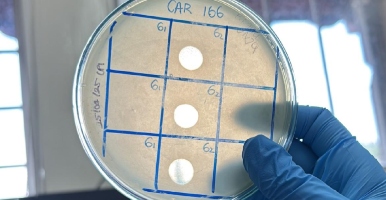
A guide to the insects and fungi of Porce II and Porce III

Z7_89C21A40L8U7A0A6HN0K3K06F7
Inglés UdeA - Cabezote - WCV(JSR 286)
Z7_89C21A40L8U7A0A6HN0K3K06V6
Index Signpost
Home
Z7_89C21A40L8U7A0A6HN0K3K06V5
UdeA - Rotador Interno (Home2) - WCV(JSR 286)
Z7_89C21A40L8U7A0A6HN0K3K06V7
UdeA - Título de sección - WCV(JSR 286)
News
Z7_89C21A40L8U7A0A6HN0K3K0M04
Portal U de A - Destacados Home 2 - WCV(JSR 286)
Z7_NQ5E12C0LGNA50QVTT1U8FGIN1
Portal U de A - Visor de Contenido - WCV(JSR 286)
Z7_NQ5E12C0LOI3E0Q9N5P3GIUL93
Portal U de A - Visor de Contenido - WCV(JSR 286)
Z7_89C21A40L8U7A0A6HN0K3K0MG4